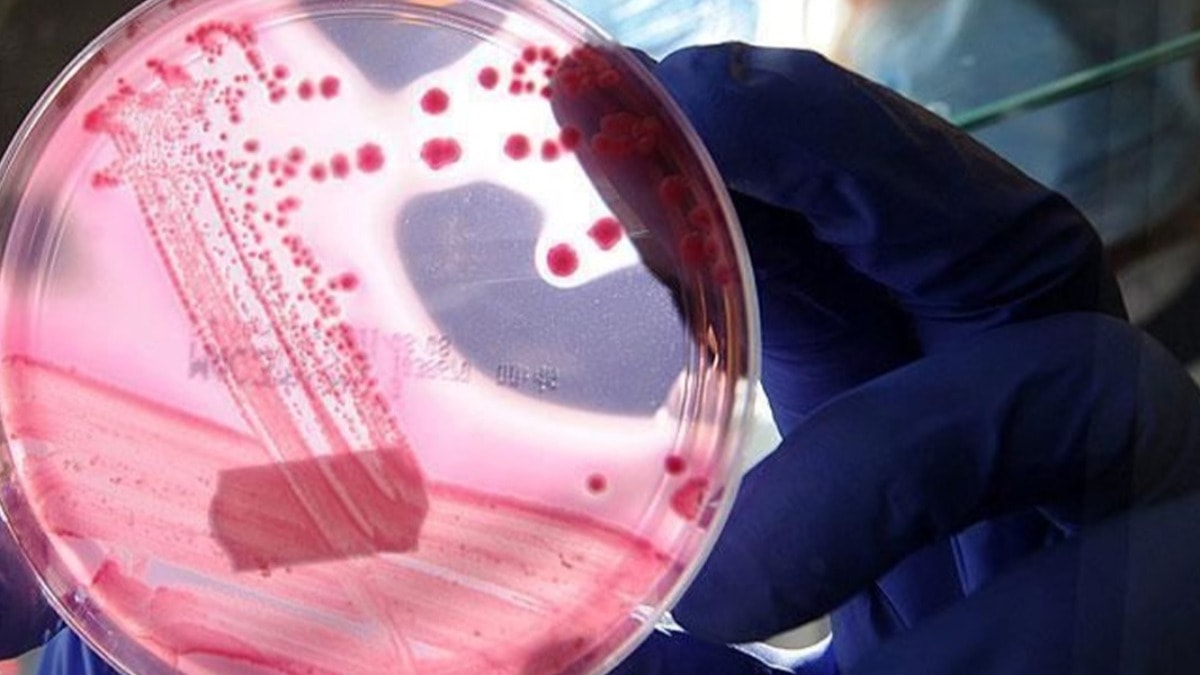

Normalde insanların kan hücrelerinde, bağışıklık sisteminin tanıdığı farklı Rh antijenleri bulunur. Ancak altın kan grubunda bu antijenlerin hiçbiri yoktur. Bu nedenle Rhnull kanı, Rh sistemi içindeki tüm nadir gruplara uyum sağlayabiliyor. Yani bu kan, birçok hasta için hayat kurtarıcı 'evrensel donör' anlamına geliyor.
KAN BANKALARININ EN DEĞERLİ HAZİNESİ
Dünyada bu kadar az kişide bulunduğu için altın kan, tıp dünyasında 'dünyanın en değerli kanı' unvanıyla da biliniyor. Uluslararası kan bankaları, Rhnull kanını acil durumlar için özel koşullarda saklıyor. Bir ünite bile, nadir kan grubuna sahip bir hastanın hayatını kurtarabiliyor.
Uzmanlara göre bu kan grubuna sahip kişilerin bağış yapması hayati önem taşıyor ancak aynı zamanda bu kişiler için kan bulmak da son derece zor. Çünkü kendi gruplarına uygun tek kan, yine altın kandan geliyor.
İLK KEZ 1961'DE TESPİT EDİLDİ
Rhnull kanı ilk kez 1961 yılında Avustralya'da bir Aborjin kadında keşfedildi. O günden bu yana yalnızca birkaç düzine vaka kayda geçti. Dünya Sağlık Örgütü (WHO) ve farklı ülkelerdeki kan merkezleri, bu kişileri özel bir kayıt altında tutuyor.
KENDİLERİNE UYGUN KAN BULAMIYORLAR
Altın kan, nakillerde 'evrensel' kabul edilse de bu gruba sahip kişiler için büyük bir dezavantaj da bulunuyor: Kendilerine uygun kan bulmaları neredeyse imkansız. Bu nedenle Rhnull taşıyanların kan bağışı ve sağlık kayıtları uluslararası düzeyde büyük bir titizlikle takip ediliyor.
Tıp literatüründe altın kan, bazen "transfüzyon biliminin kutsal kasesi" olarak adlandırılıyor. Çünkü sadece kan nakli için değil, aynı zamanda yeni tedavi yöntemlerinin araştırılmasında da eşsiz bir kaynak sağlıyor.